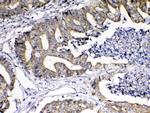
GITRL Antibody in Immunohistochemistry (Paraffin) (IHC (P))

Search
Invitrogen
GITRL Polyclonal Antibody
{{$productOrderCtrl.translations['antibody.pdp.commerceCard.promotion.promotions']}}
{{$productOrderCtrl.translations['antibody.pdp.commerceCard.promotion.viewpromo']}}
{{$productOrderCtrl.translations['antibody.pdp.commerceCard.promotion.promocode']}}: {{promo.promoCode}} {{promo.promoTitle}} {{promo.promoDescription}}. {{$productOrderCtrl.translations['antibody.pdp.commerceCard.promotion.learnmore']}}
图: 1 / 4
GITRL Antibody (PA5-80168) in IHC (P)

Please note: We are reviewing Western blot images included in the antibody testing data in our catalog, including those provided by third parties. Unless expressly labeled or annotated as “raw-unedited”, Western blot images included in the antibody testing data in our catalog may have been edited, optimized or otherwise adjusted for presentation.
产品信息
PA5-80168
种属反应
宿主/亚型
分类
类型
抗原
偶联物
形式
浓度
规格
纯化类型
保存液
内含物
保存条件
运输条件
RRID
产品详细信息
Reconstitute with 0.2 mL of distilled water to yield a concentration of 500 µg/mL.
Positive Control - IHC: human colon cancer tissue, human lung cancer tissue, human mammary cancer tissue.
靶标信息
The tumor necrosis factor (TNF) and TNF receptor (TNFR) gene superfamilies regulate numerous biological functions including cell proliferation, differentiation, and survival through regulating the activation of the transcription factor NF-kappa-B and various mitogen-activated protein kinases. The glucocorticoid-induced tumor necrosis factor receptor (GITR) is an emerging member of this family that is expressed on CD4+ CD25+ regulatory T cells and appears to have crucial immune regulation functions. Its ligand GITRL is expressed in endothelial and antigen-presenting cells and can activate NF-kappa-B, induce both pro- and anti-apoptotic effects, inhibit the suppressive activity of regulatory T cells, and co-stimulate responder T cells through GITR. Dominant negative forms of NIK and TRAF2 expressed in transfected 293 cells substantially inhibited NF-kappa-B activation, suggesting that the GITRL-GITR pathway involves both NIK and TRAF2.
仅用于科研。不用于诊断过程。未经明确授权不得转售。
篇参考文献 (0)
生物信息学
蛋白别名: Activation-inducible TNF-related ligand; AITRL; GITRLigand; Glucocorticoid-induced TNF-related ligand; hGITRL; RP1-15D23.1; TNF superfamily member 18; Tumor necrosis factor ligand superfamily member 18
基因别名: AITRL; GITRL; TL6; TNFSF18; UNQ149/PRO175
Entrez Gene ID: (Human) 8995




